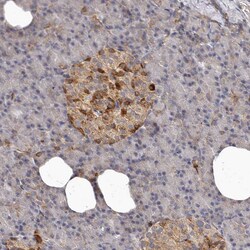
Invitrogen Bax Polyclonal Antibody 100 &mu;L | Buy Online | Invitrogen&trade; | Fisher Scientific
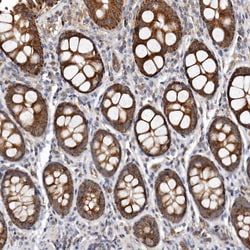
Invitrogen Bax Polyclonal Antibody 100 &mu;L | Buy Online | Invitrogen&trade; | Fisher Scientific

missing translation for 'onlineSavingsMsg'
Läs mer
Läs mer
Invitrogen™ Bax Polyclonal Antibody


Beskrivning
Immunogen sequence: GPTSSEQIMK TGALLLQGFI QDRAGRMGGE APELALDPVP QDASTKKLSE CLKRIGDELD SNMELQRMIA AVDTDSPREV FFRVAADMFS DGNFNW Highest antigen sequence indentity to the following orthologs: Rat - 88%, Mouse - 90%.
BAX is a members of the Bcl-2 Family and plays an important role in regulation of apoptosis. Whereas Bcl-2 is commonly regarded as an anti-apoptotic protein, BAX is considered to have a pro-apoptotic function. Regulation of apoptosis is supposed to involve both homo- and heterodimerization of different isoforms of BAX and Bcl-2. The Bax gene encodes different isoforms including Bax alpha (21 kDa) and Bax beta (24 kDa), whereas both isoforms contain the BH1, BH2 and BH3 domains, Bax beta has a unique carboxyl terminus and does not contain a hydrophobic transmembrane domain. Bcl-2 is also expressed in different Isoforms. Bcl-2 beta differs in the 3' UTR and coding region compared to variant alpha. Bcl-2 beta is shorter (22 kDa) and has a distinct C-terminus compared to Bcl-2 alpha (26 kDa). BAX is a member of the BCL-2 family of proteins, which function as regulators of apoptosis. Overexpression of BAX functions to promote cell death. BAX can form homodimers and is also able to heterodimerize with other BCL-2 related proteins.

Specifikationer
Specifikationer
| Antigen | Bax |
| Användningsområden | Immunohistochemistry (Paraffin), Western Blot |
| Klassificering | Polyclonal |
| Koncentration | 0.1 mg/mL |
| Konjugera | Unconjugated |
| Formulering | PBS with 40% glycerol and 0.02% sodium azide; pH 7.2 |
| Gen | BAX |
| Genaccessionsnr. | Q07812 |
| Gene Alias | apoptosis regulator BAX; Apoptosis regulator Bcl-X; Bax; Bax zeta; BAX-ALPHA; Bax-alpha protein; Baxdelta2G9; Baxdelta2G9omega; Baxdelta2omega; BCL2 associated X protein; BCL2 associated X, apoptosis regulator; BCL2 like 1; BCL2-associated protein; Bcl-2-associated protein Bax; Bcl2-associated protein Bax; Bcl-2-associated X protein; BCL2-associated X protein; BCL2-associated X protein omega; BCL2L; BCL2L1; Bcl2-L-1; BCL2L4; Bcl2-L-4; BCL2-like 1; bcl-2-like protein 1; Bcl-2-like protein 4; BCLX; Bcl-X; BCL-XL/S; PPP1R52; protein phosphatase 1, regulatory subunit 52 |
| Gensymboler | BAX |
| Visa mer |
Produkttitel
By clicking Submit, you acknowledge that you may be contacted by Fisher Scientific in regards to the feedback you have provided in this form. We will not share your information for any other purposes. All contact information provided shall also be maintained in accordance with our Privacy Policy.
Spot an opportunity for improvement?